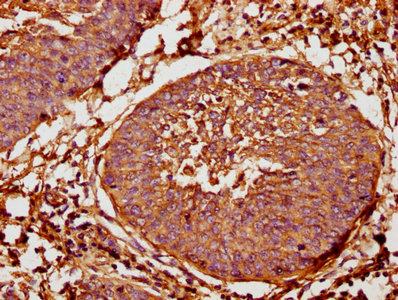

TAP2 Antibody
-
中文名稱(chēng):TAP2兔多克隆抗體
-
貨號(hào):CSB-PA22539A0Rb
-
規(guī)格:¥440
-
圖片:
-
IHC image of CSB-PA22539A0Rb diluted at 1:400 and staining in paraffin-embedded human cervical cancer performed on a Leica BondTM system. After dewaxing and hydration, antigen retrieval was mediated by high pressure in a citrate buffer (pH 6.0). Section was blocked with 10% normal goat serum 30min at RT. Then primary antibody (1% BSA) was incubated at 4°C overnight. The primary is detected by a biotinylated secondary antibody and visualized using an HRP conjugated SP system.
-
-
其他:
產(chǎn)品詳情
-
產(chǎn)品名稱(chēng):Rabbit anti-Homo sapiens (Human) TAP2 Polyclonal antibody
-
Uniprot No.:
-
基因名:
-
別名:ABC transporter, MHC 2 antibody; ABC18 antibody; ABCB3 antibody; Antigen peptide transporter 2 antibody; APT2 antibody; ATP binding cassette, sub family B (MDR/TAP), member 3 antibody; ATP-binding cassette sub-family B member 3 antibody; D6S217E antibody; Peptide supply factor 2 antibody; Peptide transporter involved in antigen processing 2 antibody; Peptide transporter PSF2 antibody; Peptide transporter TAP2 antibody; PSF 2 antibody; PSF-2 antibody; PSF2 antibody; Really interesting new gene 11 protein antibody; RING 11 antibody; RING11 antibody; TAP 2 antibody; Tap2 antibody; TAP2_HUMAN antibody; Transporter 2 ATP binding cassette sub family B antibody; Transporter 2, ABC (ATP binding cassette antibody; Transporter 2, ATP binding cassette, sub family B (MDR/TAP) antibody
-
宿主:Rabbit
-
反應(yīng)種屬:Human
-
免疫原:Recombinant Human Antigen peptide transporter 2 protein (473-615AA)
-
免疫原種屬:Homo sapiens (Human)
-
標(biāo)記方式:Non-conjugated
本頁(yè)面中的產(chǎn)品,TAP2 Antibody (CSB-PA22539A0Rb),的標(biāo)記方式是Non-conjugated。對(duì)于TAP2 Antibody,我們還提供其他標(biāo)記。見(jiàn)下表:
-
克隆類(lèi)型:Polyclonal
-
抗體亞型:IgG
-
純化方式:>95%, Protein G purified
-
濃度:It differs from different batches. Please contact us to confirm it.
-
保存緩沖液:Preservative: 0.03% Proclin 300
Constituents: 50% Glycerol, 0.01M PBS, pH 7.4 -
產(chǎn)品提供形式:Liquid
-
應(yīng)用范圍:ELISA, IHC
-
推薦稀釋比:
Application Recommended Dilution IHC 1:200-1:500 -
Protocols:
-
儲(chǔ)存條件:Upon receipt, store at -20°C or -80°C. Avoid repeated freeze.
-
貨期:Basically, we can dispatch the products out in 1-3 working days after receiving your orders. Delivery time maybe differs from different purchasing way or location, please kindly consult your local distributors for specific delivery time.
-
用途:For Research Use Only. Not for use in diagnostic or therapeutic procedures.
相關(guān)產(chǎn)品
靶點(diǎn)詳情
-
功能:ABC transporter associated with antigen processing. In complex with TAP1 mediates unidirectional translocation of peptide antigens from cytosol to endoplasmic reticulum (ER) for loading onto MHC class I (MHCI) molecules. Uses the chemical energy of ATP to export peptides against the concentration gradient. During the transport cycle alternates between 'inward-facing' state with peptide binding site facing the cytosol to 'outward-facing' state with peptide binding site facing the ER lumen. Peptide antigen binding to ATP-loaded TAP1-TAP2 induces a switch to hydrolysis-competent 'outward-facing' conformation ready for peptide loading onto nascent MHCI molecules. Subsequently ATP hydrolysis resets the transporter to the 'inward facing' state for a new cycle. Typically transports intracellular peptide antigens of 8 to 13 amino acids that arise from cytosolic proteolysis via IFNG-induced immunoproteasome. Binds peptides with free N- and C-termini, the first three and the C-terminal residues being critical. Preferentially selects peptides having a highly hydrophobic residue at position 3 and hydrophobic or charged residues at the C-terminal anchor. Proline at position 2 has the most destabilizing effect. As a component of the peptide loading complex (PLC), acts as a molecular scaffold essential for peptide-MHCI assembly and antigen presentation.
-
基因功能參考文獻(xiàn):
- Our findings support the hypothesis that hsa-miR-1270 suppresses the production of TAP2 by binding to this SNP in the 3'-UTR of this gene PMID: 29205500
- The present study illustrated that the carriage of LMP7 rs2071543-AA and TAP2 rs1800454-AA had a negative effect on treatment response to pegIFN-alpha/RBV among genotype 1 patient with chronic hepatitis C (CHC) in a Chinese Han population PMID: 29039469
- We replicated the association between the rs2071473 genotype and TAP2 expression by using GTEx data and demonstrated that TAP2 is expressed by decidual stromal cells at the maternal-fetal interface. PMID: 27745831
- Two eSNPs were associated with fecundability at a FDR of 5%; both were in the HLA region and were eQTLs for the TAP2 gene (P = 1.3x10-4) and the HLA-F gene (P = 4.0x10-4), respectively. PMID: 27447835
- These results suggest that TAP2 polymorphisms influence TB susceptibility in a Japanese population. PMID: 27325005
- Deletions of ABCB3 predict good tumor response to neoadjuvant chemotherapy in breast cancer. PMID: 26799285
- TAP/TPN complex formation is driven by hydrophobic interactions via leucine zipper-like motifs. PMID: 26519531
- TAP2, HLA-DOA, HLA-DOB, and tapasin loci are novel candidate regions for susceptibility to HCV infection and viral clearance in the Chinese population PMID: 25874709
- We showed that TAP2 gene has an association with pulmonary tuberculosis in Koreans. PMID: 25846714
- Our meta-analyses suggested that TAP2-379Ile allele was significantly associated with a 59% increased risk for rheumatoid arthritis PMID: 24972609
- Results suggested an association between TAP2-565 polymorphism and chronic lymphoid leukemia (CLL). TAP2-665 GG genotype might be a risk factor for CLL, chronic myeloblastic leukemia, and multiple myeloma. PMID: 24175803
- Three tapasin binding sites on TAP have been described, two of which are located in the N-terminal domains of TAP1 and TAP2. PMID: 24501197
- Although lung cancer cells bearing the preprocalcitonin ppCT(16-25) epitope display low levels of TAP, restoration of TAP expression inhibits ppCT antigen presentation. PMID: 23302073
- the N-terminal region of Snm1B forms a complex containing PSF2 and Mus81, while the C-terminal region is important for PSF2-mediated chromatin association. PMID: 23189151
- Genetic variation in TAP2 was associated with NHL risk overall, and follicular lymphoma risk in particular, and this was independent of other established loci from 6p21.3. PMID: 22911334
- the N-terminal extension of the TAP2 subunit represents an autonomous domain, which is correctly targeted to and inserted into the endoplasmic reticulum membrane PMID: 22638925
- Comparison of unpaired 50 primary breast cancer and 33 brain metastases showed lower expression of beta2-microglobulin, transporter associated with antigen processing (TAP) 1, TAP2 and calnexin in the brain lesions. PMID: 22065046
- Regression analysis revealed that polymorphisms and haplotypes of TAP2 were associated with FEV1 decline by aspirin provocation (P=0.002-0.04) in most of minor homozygotes compared with major homozygotes and AERD development. PMID: 21796142
- genetic polymorphism is associated with end stage renal disease in patients of North India PMID: 21440064
- Single cysteine residue within the antigen translocation complex TAP controls the epitope repertoire by stabilizing a receptive conformation. PMID: 20439763
- The higher frequency of HLA class I antigen and TAP down-regulation in metastases play a role in the clinical course of the disease. PMID: 20204276
- TAP-impaired HLA class I expression could influence the course of SCC originating in chronic ulcers and could be related to escape from cytotoxic T-lymphocyte surveillance during disease progression. PMID: 20083708
- Analysis of TAP2 polymorphisms in Finnish individuals with type I diabetes. PMID: 11916171
- There was a significant difference in the frequencies at position 665 of TAP 2 gene. TAP genes might have modifying effects on the cystic fibrosis phenotype. PMID: 12026214
- TAP2*Bky2 or its haplotype with DRB1*08032 may be involved in SS-A/Ro antibody production not only in SS but also SLE, indicating that TAP2*Bky2 may be a susceptible gene not only to the disease of SS but also to the SS-A/Ro autoantibody production. PMID: 12729048
- Expression of TAP2 is not identical to TAP1 in primary melanoma lesions. PMID: 12777979
- this allele is preferentially associated with the large conserved haplotype HLA DQA1*0501-DQB1*0201-DRB1*0301 and restricted to populations of African origin PMID: 12786999
- detected the presence of 17 nucleotide sequence variations in the entire coding region of TAP2 in an indigenous Zimbabwean population (Shona ethnic group) PMID: 12826376
- TAP2 gene polymorphism is not linked to renal cell carcinoma PMID: 12963978
- The results of this study provide genetic evidence that TAP2 gene codon 565 polymorphism may play a role in rheumatoid arthritis. PMID: 14749980
- Evidence is provided that that the extended haplotype of TAP2 is distinct in pauciarticular and polyarticular rheumatoid factor negative juvenile idiopathic arthritis patients. PMID: 15343265
- TAP1-2 gene polymorphisms may, by way of post-transcriptional changes and altered regulation of gene expression, be involve the immune system in the development of primary open-angle glaucoma PMID: 15887980
- Transmembrane segment 1 (TM1) of core-TAP2 is critical for its heterodimerization with core-TAP1. PMID: 16061226
- Results suggest the possible role of TAP2 gene polymorphism in the genetic susceptibility to systemic sclerosis . PMID: 16112028
- TAP variants lacking TAP2 N-terminal domain build peptide-loading complexes (PLC) that fail to generate stable MHC I-peptide complexes, which correlates with a substantially reduced recruitment of accessory chaperones into the PLC PMID: 16210614
- The TAP2-2 MspI polymorphism might be associated with calcium stone disease. PMID: 16215317
- Several TAP gene polymorphisms were examined and a TAP2 SNP (rs241448) associated with AD found in two independent case-control samples, especially in carriers of the APOE4 allele. PMID: 16595160
- Two Pemphigus vulgaris (PV) TAP2 risk alleles were identified (TAP2*C and TAP2*D) implying that TAP2 genes are involved in susceptibility to development of PV. PMID: 16690408
- These data reveal that the single-site polymorphism of the TAP2 gene at codon 665 may be an indicator for predicting Graves Disease development. PMID: 16721835
- The main active site required for peptide translocation by TAP1-TAP2 complexes resides at the TAP2 nucleotide binding site. PMID: 17068338
- Evidence of TAP2 association with type 1 diabetes that is independent of HLA DR-DQ may be based on allele dependence of splicing into isoforms known to have differential peptide selectivities. PMID: 17192492
- TAP2-651 site is associated with the risk of HBV infection PMID: 17525827
- First report on the role of TAP2 polymorphisms involved in the diverse pathogenesis of dengue virus infection. PMID: 18071882
- Allele 665 is associated with cervical cancer, but this is strongly influenced by linkage disequilibrium with human leukocyte antigen DQB1. PMID: 18650831
- Downregulation of TAP2 is associated with acute myeloid leukaemic blasts. PMID: 19148137
顯示更多
收起更多
-
相關(guān)疾病:Bare lymphocyte syndrome 1 (BLS1)
-
亞細(xì)胞定位:Endoplasmic reticulum membrane; Multi-pass membrane protein. Note=The transmembrane segments seem to form a pore in the membrane.
-
蛋白家族:ABC transporter superfamily, ABCB family, MHC peptide exporter (TC 3.A.1.209) subfamily
-
數(shù)據(jù)庫(kù)鏈接:
Most popular with customers
-
-
-
-
-
-
-
-
VDAC1 Recombinant Monoclonal Antibody
Applications: ELISA, WB, IHC
Species Reactivity: Human, Mouse, Rat